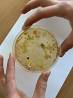
náhled Molekulární biologie v&nbsp;praxi

Molekulární biologie v praxi
Dne 2. května se čtyřčlenná skupina žáků 3.E a 4.E s doprovázena panem učitelem Marcosem vydala na vzdělávací praxi do laboratoří VŠCHT v Praze. Náplní projektu bylo, aby si středoškolští žaci vyzkoušeli práci v biochemické laboratoři a seznámili se s tzv. PCR metodou, která se užívá jak v potravinářství, tak například ve forenzní vědě. Vyzkoušeli jsme si práci s odborným vybavením pod dohledem místních profesorů, kteří se nám po celou dobu věnovali. Prostoje mezi fázemi pokusu byli vyplněné zajímavou přednáškou o škole. Byla to skvělá možnost seznámit se s nekterými profesory a s prostředím VŠCHT jako takovým.
text: Kristýna Šuhajdová a Adéla Široká (3.E)
foto: Marcos Menéndez, Kristýna Šuhajdová a Adéla Široká (3.E)
Fotogalerie

























Odkazy
Časopik

Časopik no. 5
(pdf, 3,5 MB)

 www.facebook.com/
www.facebook.com/
peveckysborglp
SOČ Plzeňského kraje

www.glp.cz/socka
Matematická olympiáda
Plzeňského kraje

www.glp.cz/mo
Krajský parlament dětí a mládeže PK
![]()
 parlament.radovanek.cz
parlament.radovanek.cz
Dotace na projekty
Zpíváme Vám pro radost XII
Festival španělského divadla v Plzni
Mikrogrant - elektronické klávesy

 umo4.plzen.eu
umo4.plzen.eu
XVI. ročník národního
festivalu studentského
divadla ve španělštině

 www.pltep.cz
www.pltep.cz

 www.vodarna.cz
www.vodarna.cz
Charity
Diakonie - chcete být dobrovolníkem?
![]()
 www.diakoniezapad.cz
www.diakoniezapad.cz
Člověk v tísni
regionální pobočka Plzeň

 www.clovekvtisni.cz
www.clovekvtisni.cz
Diecézní charita Plzeň

 www.dchp.cz
www.dchp.cz
 Prohlášení o přístupnosti
Prohlášení o přístupnosti 
 Español
Español
 English
English Deutsch
Deutsch